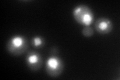
YOR117W

View description
One of six ATPases of the 19S regulatory particle of the 26S proteasome involved in the degradation of ubiquitinated substrates; recruited to the GAL1-10 promoter region upon induction of transcription
Localization:
Intensity:
Fold change:
Significance:
-
C’ GFP library in SD

nucleus135.82 -
N' NOP1pr-GFP in SD

N/A0 -
N' TEF2pr-mCherry in SD

N/A0 -
N' NATIVEpr-GFP in SD

N/A0 -
N' TEF2pr-VC and Cyto-VN in SD

N/A0 -
C’ GFP library in SD+DTT
nucleus120.820.88No -
C’ GFP library in SD+H2O2

nucleus161.81.19No -
C’ GFP library in Starvation Media

nucleus74.880.55Yes -
C’ GFP library on the background of Pup2-DaMP

nucleus -
C’ GFP library on the background of CCT mutant

nucleus140.0211.03083No
